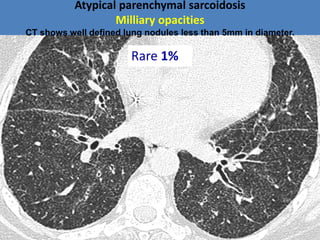
Atypical parenchymal sarcoidosis
Milliary opacities
CT shows well defined lung nodules less than 5mm in diameter.
Rare 1%

Sarcoidosis is a multisystem disorder characterized by non-caseating granulomas. It most commonly affects the lungs (90% of cases) and lymph nodes (70% of cases). The pathogenesis involves an abnormal immune response in genetically predisposed individuals, leading to granuloma formation. Clinically, sarcoidosis often presents as asymptomatic bilateral hilar lymphadenopathy on chest imaging. Lung involvement can range from isolated interstitial involvement to fibrosis. Skin and eye involvement are also common. The diagnosis is made by biopsy demonstrating non-caseating granulomas in the absence of infections or malignancy. The course is variable but most cases resolve spontaneously without sequelae.